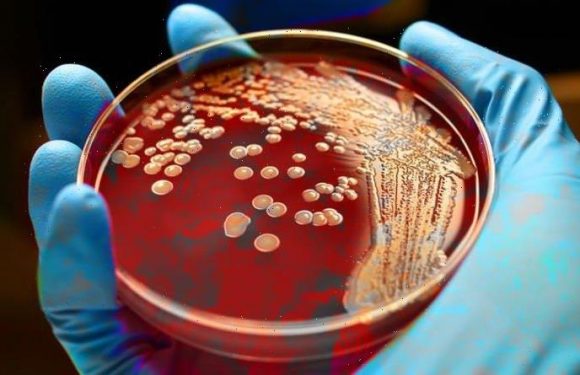
MRSA breakthrough: Revolutionary wonderdug to kill antibiotic-resistant hospital superbug

Sky unveils Glass – a no-dish, no-box TV from £39/month
Say goodbye to the satellite dish! Sky unveils Glass – a no-dish, no-box TV complete with built-in Sky services from £39/month Sky has launched its first television that comes with built-in streaming services It means that customers won’t need a satellite dish…